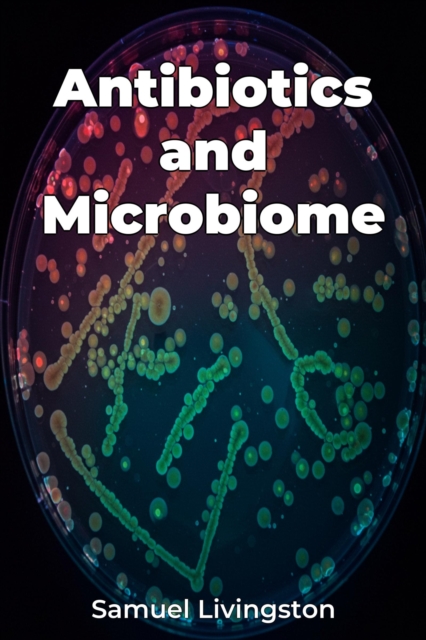
Antibiotics and Microbiome

Antibiotics and Microbiome
Antibiotics and Microbiome explores the complex and crucial relationship between antibiotic use and the human microbiome—the vast community of microorganisms living within us. While antibiotics are vital for fighting bacterial infections, their widespread use significantly impacts the diversity and stability of our microbial ecosystems. The book reveals how antibiotics can disrupt the delicate bal...
Antibiotics and Microbiome explores the complex and crucial relationship between antibiotic use and the human microbiome—the vast community of microorganisms living within us. While antibiotics are vital for fighting bacterial infections, their widespread use significantly impacts the diversity and stability of our microbial ecosystems. The book reveals how antibiotics can disrupt the delicate bal...
